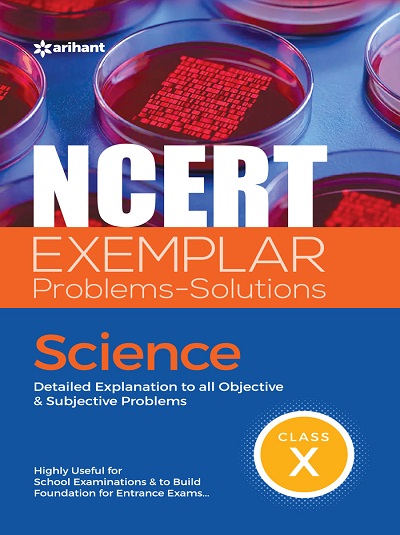
NCERT EXEMPLAR Problems-Solutions For Class 10th SCIENCE | Arihant Publications

Class 10th - NCERT Textbooks/Guides/Paper Sets
64 titles found

NEW (20%)
CBSE Perfect Prep हिंदी ब स्पर्श व संचयन भाग २ (Hindi B) Std. X/Std. 10 | Target Publications

NEW (20%)
CBSE Perfect Prep SOCIAL SCIENCE Std. X/Std. 10 | Target Publications

NEW (20%)
CBSE Perfect Prep ENGLISH (Language And Literature) Std. X/Std. 10 | Target Publications

NEW (20%)
CBSE MATHEMATICS Vol. II (NCERT) Std. X/Std. 10 | Target Publications

NEW (15%)
NCERT EXEMPLAR PROBLEMS-SOLUTIONS For Class 10th SCIENCE | OSWAAL BOOKS

NEW (15%)
NCERT EXEMPLAR PROBLEMS-SOLUTIONS For Class 10th MATHEMATICS | OSWAAL BOOKS
NEW (20%)
NCERT EXEMPLAR Problems-Solutions For Class 10th SCIENCE | Arihant Publications

NEW (15%)
NCERT SOLUTIONS MATHEMATICS For CLASS 10th | AMIT RASTOGI, SANJEEV JAIN | Arihant Publications

NEW
NCERT SOLUTIONS SCIENCE For CLASS 10th | SK SINGH, GEETIKA KHANNA, DR. KANCHAN UPRETI | Arihant Publications

NEW (10%)
SCIENCE PART-1 PHYSICS - For Class 10th | LAKHMIR SINGH, MANJIT KAUR | S.CHAND
ICSE BORD

NEW (10%)
SCIENCE PART-2 CHEMISTRY - For Class 10th | LAKHMIR SINGH, MANJIT KAUR | S.CHAND
ICSE BORD

NEW (10%)
SCIENCE PART-3 BIOLOGY - For Class 10th | LAKHMIR SINGH, MANJIT KAUR | S.CHAND
ICSE BORD
